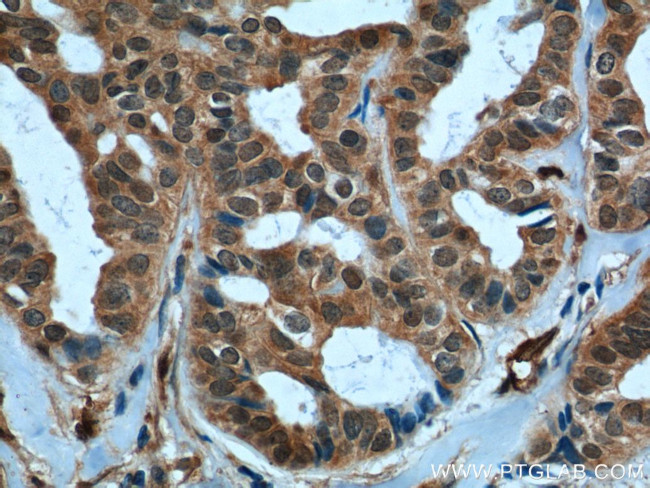
TAZ Antibody in Immunohistochemistry (Paraffin) (IHC (P))

Search
Proteintech
TAZ Polyclonal Antibody
{{$productOrderCtrl.translations['antibody.pdp.commerceCard.promotion.promotions']}}
{{$productOrderCtrl.translations['antibody.pdp.commerceCard.promotion.viewpromo']}}
{{$productOrderCtrl.translations['antibody.pdp.commerceCard.promotion.promocode']}}: {{promo.promoCode}} {{promo.promoTitle}} {{promo.promoDescription}}. {{$productOrderCtrl.translations['antibody.pdp.commerceCard.promotion.learnmore']}}
产品信息
23306-1-AP
种属反应
已发表种属
宿主/亚型
分类
类型
抗原
偶联物
形式
浓度
规格
纯化类型
保存液
内含物
保存条件
运输条件
产品详细信息
Immunogen sequence: MNPASAPPP LPPPGQQVIH VTQDLDTDLE ALFNSVMNPK PSSWRKKILP ESFFKEPDSG SHSRQSSTDS SGGHPGPRLA GGAQHVRSHS SPASLQLGTG AGAAGSPAQQ HAHLRQQSYD VTDELPLPPG WEMTFTATGQ RYFLNHIEKI TTWQDPRKAM NQPLNHMNLH PAVSSTPVPQ RSMAVSQPNL VMNHQHQQQM APSTLSQQNH PTQNPPAGLM SMPNALTTQQ QQQQKLRLQR IQMERERIRM RQEELMRQEA ALCRQLPMEA ETLAPVQAAV NPPTMTPDMR SITNNSSDPF LNGGPYHSRE QSTDSGLGLG CYSVPTTPED FLSNVDEMDT GENAGQTPMN INPQQTRFPD FLDCLPGTNV DLGTLESEDL IPLFNDVESA LNKSEPFLTW L (1-400 aa encoded by BC014052)
靶标信息
WW domain-containing transcription regulator protein 1 (WWTR1) is a transcriptional coactivator which acts as a downstream regulatory target in the Hippo signaling pathway that plays a pivotal role in organ size control and tumor supression by restricting proliferation and promoting apoptosis. The core of this pathway is composed of a kinase cascade wherein STK3/MST2 and STK4/MST1, in complex with its regulatory protein SAV1, phosphorylates and activates LATS1/2 in complex with its regulatory protein MOB1. In turn, MOB1 phosphorylates and inactivates YAP1 oncoprotein and WWTR1/TAZ. WWTR1 enhances PAX8 and NKX2-1/TTF1-dependent gene activation. WWTR1 regulates the nuclear accumulation of SMADS and has a key role in coupling them to the transcriptional machinery such as the mediator complex. WWTR1 also regulates embryonic stem-cell self-renewal and promotes cell proliferation and epithelial-mesenchymal transition.
仅用于科研。不用于诊断过程。未经明确授权不得转售。
生物信息学
蛋白别名: DKFZp586I1419; FLJ27004; FLJ45718; Tafazzin; transcriptional co-activator with PDZ-binding motif; Transcriptional coactivator with PDZ-binding motif; unnamed protein product; WW domain-containing transcription regulator protein 1
基因别名: TAZ; WWTR1
UniProt ID: (Human) Q9GZV5
Entrez Gene ID: (Human) 25937